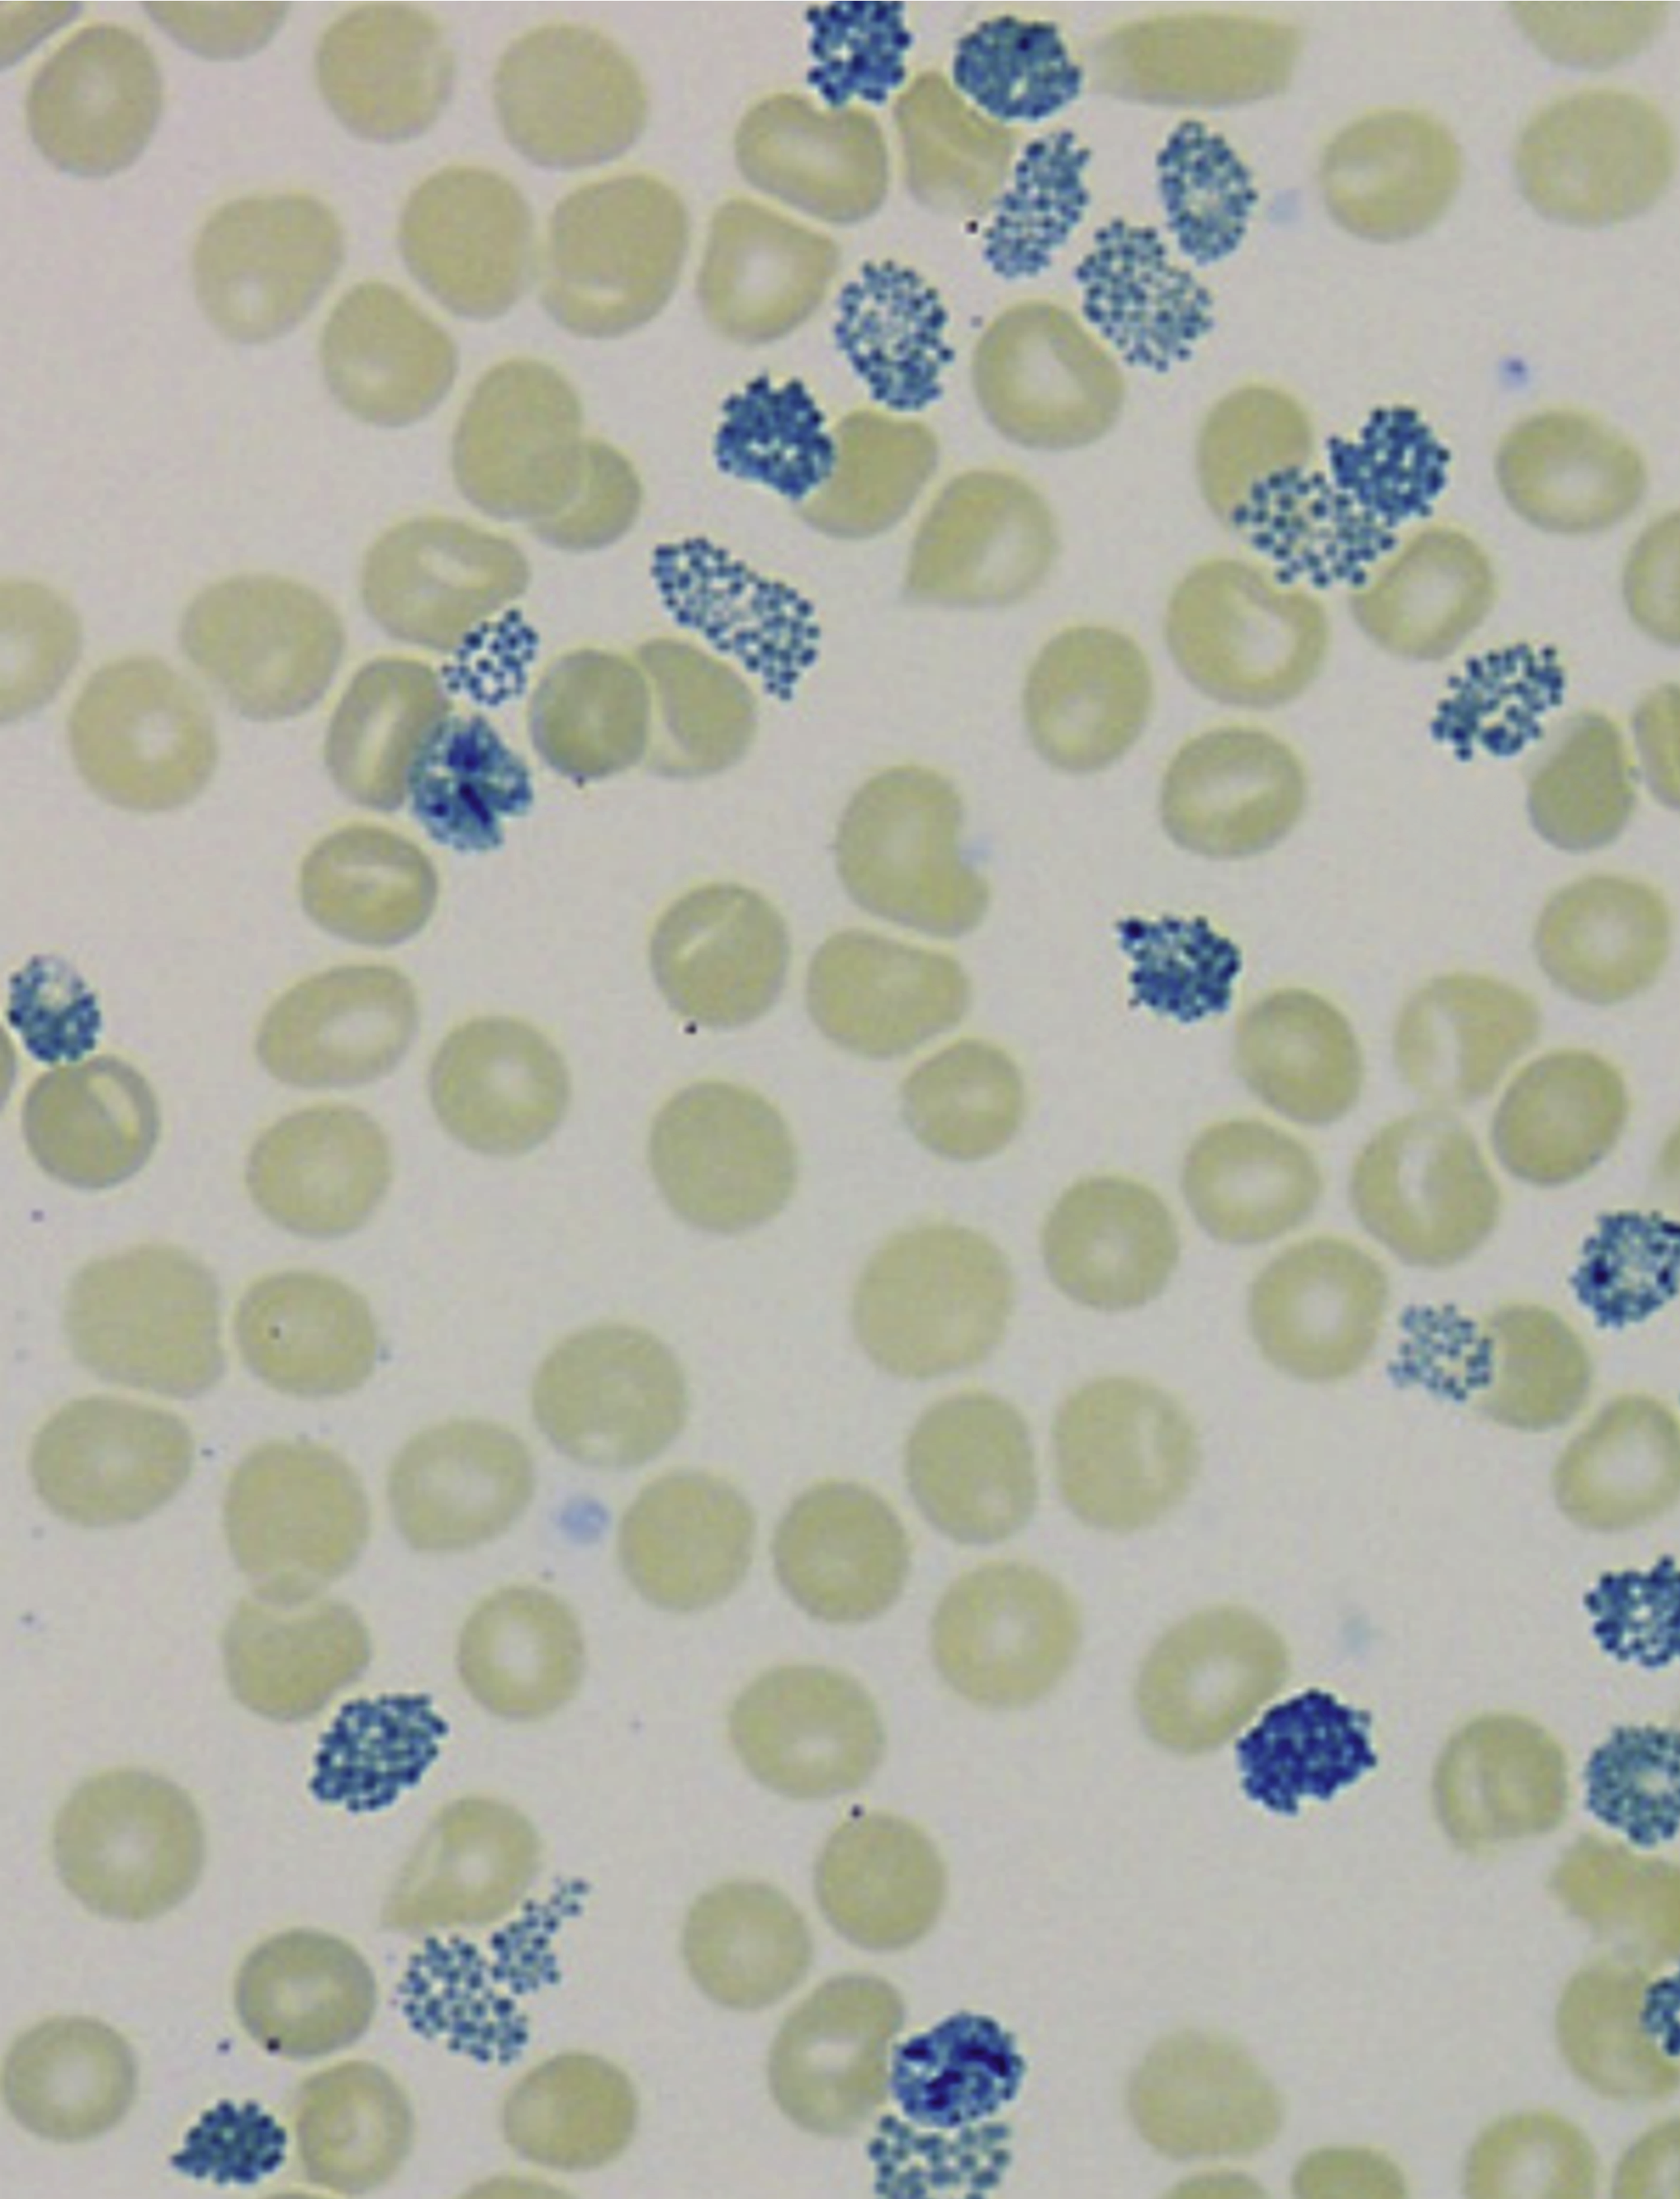
issue cover

Issue Archive
Table of Contents
EDITORIAL
Introduction to a review series on globin disorders
Introduced by Associate Editors Thomas Coates and Irene Roberts, this review series focuses on globin disorders, covering advances in our understanding of globin gene biology that have already been translated into meaningful benefit for patients as well as those with the potential for future therapeutic impact. Written by leaders in the field of α- and β-globin study, these articles collectively highlight the rewards for patients that can arise from decades of dedicated research.
BLOOD COMMENTARIES
PLENARY PAPER
Early-life infection depletes preleukemic cells in a mouse model of hyperdiploid B-cell acute lymphoblastic leukemia
The origins of childhood B-cell acute lymphoblastic leukemia (B-ALL) often begin during embryonic life when germ line or somatic mutations give rise to preleukemic stem cells. Viral infections have been demonstrated to promote leukemia development by causing second mutations. In this Plenary Paper, Farrokhi and colleagues now present the first evidence that early postnatal infection provokes an immune response that protects the host from developing B-ALL by depleting preleukemic cells. These data help explain why so few children born with preleukemic mutations subsequently suffer B-ALL.
REVIEW SERIES
Hemoglobin Bart’s hydrops fetalis: charting the past and envisioning the future
Introduced by Associate Editors Thomas Coates and Irene Roberts, this review series focuses on globin disorders, covering advances in our understanding of globin gene biology that have already been translated into meaningful benefit for patients as well as those with the potential for future therapeutic impact. Written by leaders in the field of α- and β-globin study, these articles collectively highlight the rewards for patients that can arise from decades of dedicated research.
A moonlighting job for α-globin in blood vessels
Introduced by Associate Editors Thomas Coates and Irene Roberts, this review series focuses on globin disorders, covering advances in our understanding of globin gene biology that have already been translated into meaningful benefit for patients as well as those with the potential for future therapeutic impact. Written by leaders in the field of α- and β-globin study, these articles collectively highlight the rewards for patients that can arise from decades of dedicated research.
Elevating fetal hemoglobin: recently discovered regulators and mechanisms
Introduced by Associate Editors Thomas Coates and Irene Roberts, this review series focuses on globin disorders, covering advances in our understanding of globin gene biology that have already been translated into meaningful benefit for patients as well as those with the potential for future therapeutic impact. Written by leaders in the field of α- and β-globin study, these articles collectively highlight the rewards for patients that can arise from decades of dedicated research.
Novel therapeutic approaches in thalassemias, sickle cell disease, and other red cell disorders
Introduced by Associate Editors Thomas Coates and Irene Roberts, this review series focuses on globin disorders, covering advances in our understanding of globin gene biology that have already been translated into meaningful benefit for patients as well as those with the potential for future therapeutic impact. Written by leaders in the field of α- and β-globin study, these articles collectively highlight the rewards for patients that can arise from decades of dedicated research.
CLINICAL TRIALS AND OBSERVATIONS
Seven-year outcomes of venetoclax-ibrutinib therapy in mantle cell lymphoma: durable responses and treatment-free remissions
Clinical Trials & Observations
Brief Report
Relapsed mantle cell lymphoma (MCL) portends poor prognosis, but with multiple new agents showing encouraging response rates, data on long-term outcomes are essential. Handunnetti and colleagues report on the 7-year follow-up of the first phase 2 trial of patients heavily pretreated with the combination of ibrutinib and venetoclax, documenting 30% 7-year progression-free survival and durable remissions after treatment cessation in the majority of patients who achieved measurable residual disease–negative complete remission. With the median time-off therapy approaching 5 years, this trial provides key evidence for the use of response-informed regimens combining BCL2 and Bruton tyrosine kinase inhibitors in MCL.
IMMUNOBIOLOGY AND IMMUNOTHERAPY
Efficacy of T-cell assays for the diagnosis of primary defects in cytotoxic lymphocyte exocytosis
Primary hemophagocytic lymphohistiocytosis is a hyperinflammatory disorder caused by biallelic loss-of-function mutations in genes required for CD8 T-cell and natural killer (NK)–cell cytotoxicity. Diagnosis requires a constellation of clinical and laboratory findings, including functional impairment in NK-cell cytotoxicity, which can be challenging. Chiang et al report on an encouraging novel in vitro assay that quantifies cytotoxic lymphocyte exocytosis more accurately than standard K562 cell line–based assays, warranting further assessment for routine incorporation into diagnostic workups.
MYELOID NEOPLASIA
IL-9 secreted by leukemia stem cells induces Th1-skewed CD4+ T cells, which promote their expansion
Radpour and colleagues uncover a novel mechanism by which leukemia stem cells (LSCs) hijack T helper (Th) cells in the bone marrow of patients with acute myeloid leukemia (AML), promoting their own expansion and contributing to disease progression. Using transcriptomic profiling, unbiased high-throughput correlation network analyses, and functional assays of patient bone marrow, the authors identified that interleukin-9 (IL-9) secreted by AML LSCs epigenetically activated CD4+ T cells, inducing Th1-skewing and the secretion of interferon gamma and tumor necrosis factor α, which in turn enabled LSC expansion. These data highlight IL-9 as a potential therapeutic target.
TRANSPLANTATION
GVHD targets organoid-forming bile duct stem cells in a TGF-β–dependent manner
Liver graft-versus-host disease (GVHD) frequently presents as cholestasis, commonly associated with degenerative changes of the portal bile ducts. Hasegawa et al report that liver macrophage–derived transforming growth factor-β (TGF-β) injures bile duct stem cells in mice during GVHD, resulting in impaired hepatic regeneration and function, explaining the phenotypic features seen in patients. The authors’ preclinical data argue for further examinations of the potential clinical utility of TGF-β signaling inhibitors to reduce hepatic dysfunction during GVHD.
LETTER TO BLOOD
Updated cutaneous T-cell lymphoma TNMB staging criteria fail to identify patients with Sézary syndrome with low blood burden
Clinical Trials & Observations
BLOOD WORK
-
Cover Image
Cover Image
![issue cover]()
Brilliant cresyl blue preparation of a peripheral blood smear from a transfused adolescent with α-thalassemia major, showing a dual population of transfused cells and endogenous cells with blue hemoglobin H inclusion bodies. See the article by Amid et al on page 822.
- PDF Icon Front MatterFront Matter
- PDF Icon Table of ContentsTable of Contents
- PDF Icon Editorial BoardEditorial Board
Advertisement intended for health care professionals
Email alerts
Advertisement intended for health care professionals